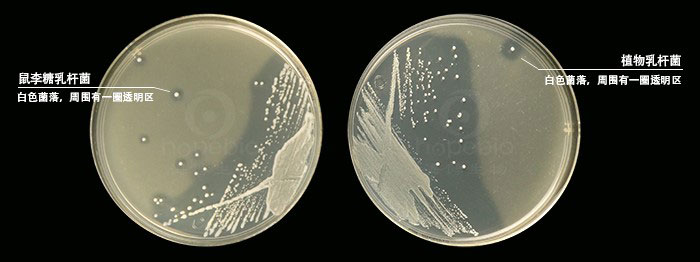
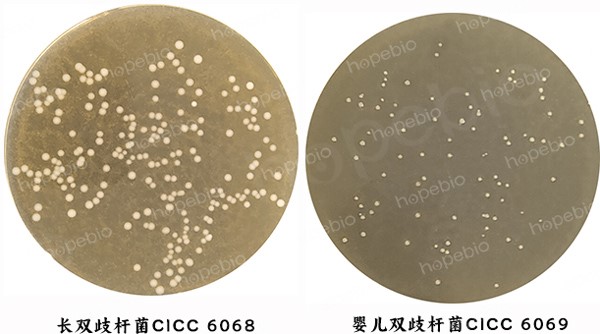

海博微信公众号
海博微信公众号
 海博天猫旗舰店
海博天猫旗舰店


 海博微信公众号
海博微信公众号
 海博天猫旗舰店
海博天猫旗舰店




在人类肉眼不可见的微观世界中,活跃着数以万亿计的微生物。最新研究显示,人体内微生物数量与人体细胞的比例约为1.3:1,这些微小生命不仅构成了复杂的生态系统,更在多个维度影响着我们的健康。随着微生物组研究的突破性进展,科学家发现这些“隐形房客”在营养代谢、免疫调节甚至情绪控制中都发挥着关键作用。
一、对人体肠道有益的菌群—益生菌
对人体肠道有益的菌群通常被称为益生菌(Probiotics),它们通过维持肠道菌群平衡、增强免疫力、促进营养吸收、缓解肠道问题、代谢调节(影响血糖、胆固醇水平,减少肥胖风险)等方式对健康产生积极影响。以下是一些主要的有益肠道菌种及其作用:
1.乳杆菌属(Lactobacillus)
乳杆菌属常见的菌种有嗜酸乳杆菌(L. acidophilus),其作用是帮助缓解乳糖不耐症,抑制病原菌生长;鼠李糖乳杆菌(L. rhamnosus),如图1所示,其作用是增强肠道屏障功能,缓解腹泻(尤其是抗生素相关性腹泻);植物乳杆菌(L. plantarum),如图1所示,其作用是减少肠道炎症,改善肠易激综合征(IBS)。这些菌种的来源主要有酸奶、发酵食品(如泡菜、酸菜)、益生菌补充剂等。
图1 鼠李糖乳杆菌和植物乳杆菌在GYP白亚琼脂培养基上的菌落特征
2.双歧杆菌属(Bifidobacterium)
双歧杆菌属常见的菌种有婴儿双歧杆菌(B. infantis),如图2所示,其作用是促进婴儿肠道发育,抑制有害菌;长双歧杆菌(B. longum),如图2所示,其作用是缓解便秘,调节免疫反应;短双歧杆菌(B. breve),其作用是改善肠道蠕动,减少胀气。这类菌属可分解膳食纤维生成短链脂肪酸(如丁酸),滋养肠道细胞,降低肠道pH值抑制病原菌,来源主要有发酵乳制品、益生菌制剂等。
图2 双歧杆菌在BBL琼脂培养基上的菌落特征;
注:①长双歧杆菌呈圆形凸起、奶油色、边缘整齐光滑;②婴儿双歧杆菌呈圆形凸起、奶油色、边缘整齐光滑。
3.其他重要菌属
布拉氏酵母菌(Saccharomyces boulardii),一种益生酵母菌,对抗生素相关性腹泻和旅行者腹泻有效;罗斯氏菌(Roseburia spp.),产生丁酸,维护肠道屏障,与抗炎作用相关;嗜黏蛋白阿克曼氏菌(Akkermansia muciniphila),降解肠道黏液蛋白,增强肠道屏障,与代谢健康(如改善肥胖、糖尿病)相关;粪杆菌属(Faecalibacterium prausnitzii),产生丁酸,具有抗炎特性,与炎症性肠病(IBD)缓解相关。
因此,我们要有意识的通过天然食物,必要时通过补充剂来为我们人体补充益生菌,如酸奶、纳豆、泡菜、康普茶;富含膳食纤维的食物(益生元),如洋葱、大蒜、香蕉、燕麦等,以滋养益生菌;选择含多种菌株、活菌数高(≥109CFU)的产品,并注意储存条件(部分需冷藏)。
二、维持皮肤微生态的有益菌
1.表皮防御体系
表皮葡萄球菌(Staphylococcus epidermidis),如图3所示,通过分泌抗菌肽抑制金黄色葡萄球菌等致病菌定植,还可通过免疫调节增强皮肤屏障功能,减少炎症反应,其产生的特异性蛋白酶还能分解引发痤疮的游离脂肪酸。

图3 表皮葡萄球菌在Baird-Parker琼脂上的菌落特征
枯草芽孢杆菌(Bacillus subtilis),如图4所示,可用于护肤品,其作用主要有抗菌、去角质、滋润肌肤:芽孢杆菌发酵产物具有抗菌功效,可以帮助改善皮肤菌群感染引起的症状;枯草芽孢杆菌酶可以消化和吸收老的角质层;芽孢杆菌发酵产物可以滋润肌肤,减少对皮肤的刺激性。

图4 枯草芽孢杆菌ATCC 6633的芽孢染色结果
注:芽孢为绿色,菌体为红色。
2.酸碱平衡
痤疮丙酸杆菌(Cutibacterium acnes,旧称Propionibacterium acnes),在正常状态下可分解皮脂生成短链脂肪酸,维持酸性环境,抑制病原菌,是皮肤微生态的关键成员,但其过度增殖可能会引发痤疮,因此维持其平衡对油性皮肤健康至关重要。
因此为维持皮肤微生态的平衡,我们要避免过度清洁,以保护菌群的多样性;补充益生元及后生元,如低聚糖或发酵产物,支持有益菌生长;个性化护肤,根据皮肤类型选择维护微生态的产品。
三、参与黏膜免疫调节的有益菌
参与人体黏膜免疫调节的有益菌主要通过调节免疫细胞活性、增强屏障功能以及抑制病原体等方式发挥作用。除了上述肠道益生菌中介绍的乳酸杆菌属、双歧杆菌属、粪球菌属、嗜黏蛋白阿克曼氏菌等可参与人体黏膜免疫调节,我们另外介绍以下几种菌:
1.呼吸道共生菌
唾液链球菌(Streptococcus salivarius)是人体口腔、上呼吸道和肠道黏膜常见的共生菌之一,具有重要的免疫调节功能,尤其在黏膜免疫系统中发挥多重作用,其作用主要有:增强黏膜屏障功能;调节免疫细胞活性;其代谢产物(短链脂肪酸、细菌素)具有免疫调节作用;抗炎、免疫耐受诱导等。其不同菌株的免疫调节效果可能差异显著,如K12侧重口腔健康、M18抑制龋齿。然而,在宿主免疫缺陷或黏膜屏障受损时,唾液链球菌可能会引发机会性感染,如菌血症。
2. 生殖道
卷曲乳杆菌(Lactobacillus crispatus)通过产乳酸维持阴道pH值3.8-4.5,其生成的过氧化氢能有效杀灭白色念珠菌,预防细菌性阴道病。
五、结语:重构人与微生物的共生智慧
在宏基因组学技术的推动下,我们正从“抗菌时代”迈入“益生时代”。美国NIH人类微生物组计划最新数据显示,人体内有益微生物种类已鉴定出超过2000种,其中30%具有潜在药用价值。理解并善用这些微生物盟友,将成为未来个性化健康管理的重要维度。正如诺贝尔奖得主Joshua Lederberg所言:“人类应该把自己视为共生超级生物体,这是进化赋予我们的终极生存智慧。”(本公司有培养以上菌种的相关培养基,详情请见表1)
表1 青岛海博生物相关产品信息
|
产品编号 |
产品名称 |
规格 |
产品说明及用途 |
|
HB8539 |
250g |
用于乳酸菌的分离培养 |
|
|
HB8636-1 |
250g |
用于植物乳杆菌的活化培养 |
|
|
HB8637-1 |
250g |
用于植物乳杆菌的增菌培养 |
|
|
HB8896 |
250g |
用于食品中叶酸测定时鼠李糖乳杆菌的活化和保存 |
|
|
HB0396 |
250g |
用于双歧杆菌的分离培养(GB标准) |
|
|
HB0397 |
250g |
用于双歧杆菌的分离培养(GB标准) |
|
|
HB0398 |
250g |
用于双歧杆菌的增菌培养(GB标准) |
|
|
HBJZ072 |
支 |
主要用于阳性对照反应和培养基质量控制等实验 |
|
|
HB9223 |
250g |
用于枯草芽孢杆菌增菌培养 |
|
|
GB179 |
20支 |
用于枯草芽孢杆菌生化试验 |
|
|
HB8562 |
250g |
用于肠球菌,轻型链球菌和唾液链球菌分离培养 |
|
|
HB8912-1 |
250g |
用于轻型唾液链球菌的分离培养 |
注:本文属海博生物原创,未经允许不得转载。
上一篇:细胞转染常用的方法及其原理
下一篇:潜伏的威胁:威胁人类健康的致病菌
| 相关文章: | ||



